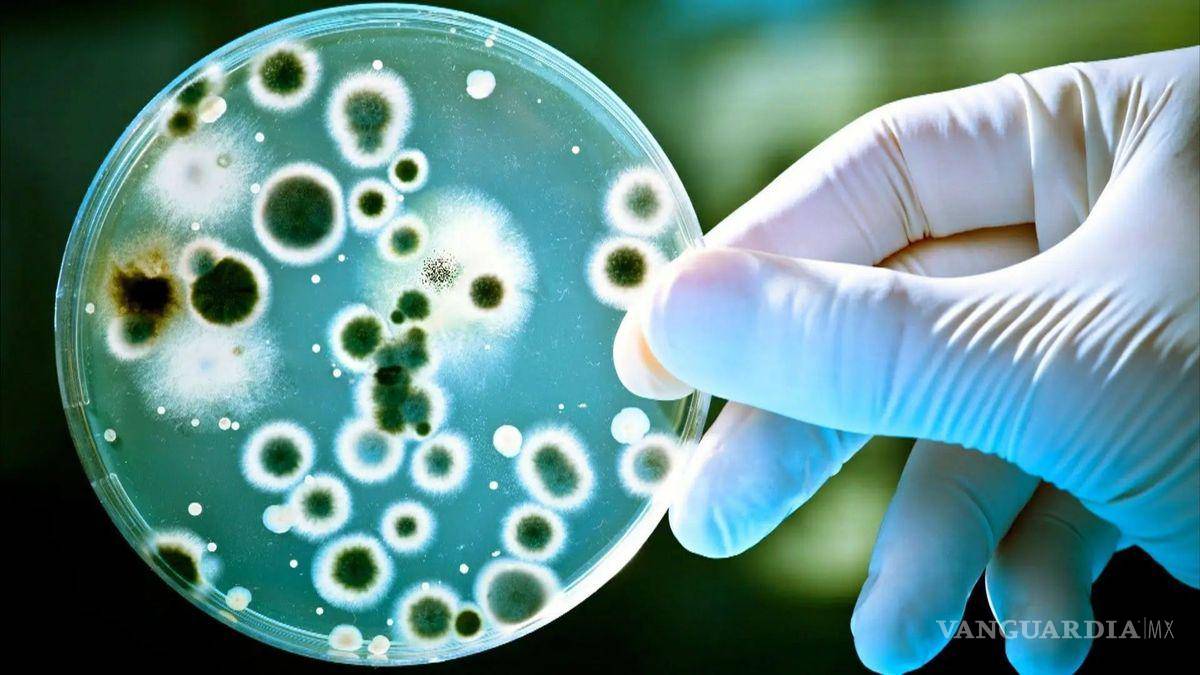

Alerta en EU y México por peligrosa bacteria que causa melioidosis, rara y mortal enfermedad... ¿Cuáles son los síntomas?
COMPARTIR
Esta bacteria, que según los especialistas es ‘potencialmente mortal’, causa la enfermedad conocida como melioidosis y puede ser encontrada en suelo y agua
Una bacteria conocida como Burkholderia pseudomallei, fue identificada recientemente en Estados Unidos, según informaron los Centros de Prevención y Control de Enfermedades (CDC, por sus siglas en inglés).
Esta bacteria, que según los especialistas es ‘potencialmente mortal’, causa la enfermedad conocida como melioidosis y puede ser encontrada en suelo y agua.
La Burkholderia pseudomallei solo se había detectado en tierra y agua en zonas de Tailandia, el norte de Australia y Puerto Rico.
TE PUEDE INTERESAR: Garrapatas... Los peligrosos virus e infecciones que puedes contraer por su mordedura
La bacteria Burkholderia pseudomallei o B. pseudomallei se identificó en muestras de suelo y agua en la región de la costa del Golfo de Mississippi. Esto después de que dos personas no relacionadas que vivían muy cerca de la zona enfermaran de melioidosis, una en 2020 y la otra en 2022.
Tras del hallazgo, los CDC alertaron a todos los médicos del país y les pidieron estar al tanto de los signos y síntomas de la enfermedad en sus pacientes.
Anteriormente, se reportó en Ecuador, El Salvador, México, Panamá, Brasil, Haití y Perú por lo que llama la atención su presencia en EU. Expertos creen que es una de las consecuencias del calentamiento global.
La melioidosis es una enfermedad zoonótica, con casos en ovinos, cerdos, caprinos, caballos, perros, delfines, peces tropicales, monos y algunos animales de zoológico.
El periodo de incubación es de pocos días, pero se han reportado casos en Asia en que el virus está inactivo por años y surge al existir otra enfermedad o cuando bajan las defensas del cuerpo, al no dar seguimiento puede presentarse como un malestar agudo fulminante, causa fiebre, dolor de articulaciones y cabeza; neumonía y gastroenteritis. También abscesos en el cuerpo e infección sanguínea.
La forma más común de contagio es a través del contacto con agua y suelo contaminados, sobre todo si hay alguna herida en la piel, también al inhalar la bacteria.
Aparece como una afección respiratoria con una letalidad de 30%.
Al año, en promedio se detectan 12 casos en EU, pero importados. Esta vez, la bacteria Burkholderia pseudomallei ha sido hallada en suelo y agua en la propiedad de un hombre en Mississipi que enfermó de melioidosis y se teme que esté en otras áreas del Golfo de México.
En el estado ya son dos casos, ambas personas vivían cerca y se recuperaron.
Los Centros para el Control y la Prevención de Enfermedades alertaron que “una vez que está en el suelo, puede ser una amenaza para la salud de la gente en el área”, y temen que broten más casos.
Síntomas de la Melioidosis
En las zonas endémicas de melioidosis hasta dos tercios de las personas tienen datos de haber estado en contacto con la bacteria a los cuatro años. Sin embargo, pocas personas sufren la enfermedad, por lo que en realidad se asume que la mayoría de las infecciones son asintomáticas o con escasos síntomas. Si acaso, se puede producir inicialmente una enfermedad similar a la gripe, que se resuelve espontáneamente, o bien la bacteria se queda latente en el organismo.
Si se produce la enfermedad sintomática, ésta puede aparecer de forma más o menos inmediata tras la infección (infección aguda). En ocasiones la bacteria se queda latente (como dormida) en el organismo y produce una infección más tarde al reactivarse. Por otro lado, si los síntomas duran más de dos meses se trata de una melioidosis crónica.
Cuando la bacteria produce enfermedad sintomática, la forma más grave de afectación es la septicemia melioidósica. Éste es un cuadro muy grave en el que se puede afectar cualquier órgano del cuerpo, incluyendo los pulmones, el hígado, el bazo, la próstata y las glándulas parótidas. Esta forma de melioidosis tiene una mortalidad global del 20% (y hasta del 50% en caso de shock séptico, y del 75% en bebés recién nacidos).
La forma más frecuente de melioidosis en adultos es la neumonía. Los síntomas de la neumonía son fiebre alta, tos con expectoración, escalofríos, tiritona, y distrés respiratorio, con o sin un cuadro grave de shock, según si la bacteria pasa a la sangre o no. En otras ocasiones los síntomas de la melioidosis pueden ser más larvados o crónicos, con tos con esputos purulentos, o con sangre y sudores nocturnos; en estos casos se puede confundir con tuberculosis.
Otros síntomas o formas de presentación de la melioidosis son:
Los abscesos y las úlceras cutáneas (forma de presentación más frecuente en niños).
Genitourinario: los síntomas son dolor por encima del pubis, molestias y dificultades al orinar (incluso se puede producir una retención aguda de orina). A menudo se inflama la próstata. Es frecuente que se acompañe de diarrea.
Artritis u osteomielitis (infección de articulaciones o huesos).Encefalomielitis: es una forma rara (4% de casos en el norte de Australia) pero muy grave, con infección del cerebro, del tronco encefálico o la médula.
Infección de otros órganos como las glándulas parótidas (sobre todo en niños en Tailandia), arterias grandes, mediastino, pericardio, glándula suprarrenal, bazo, hígado, riñón, próstata.
Adicionalmente, los pacientes con enfermedad pulmonar crónica pueden tener colonización por la bacteria, con riesgo de producir una enfermedad más grave posteriormente.








